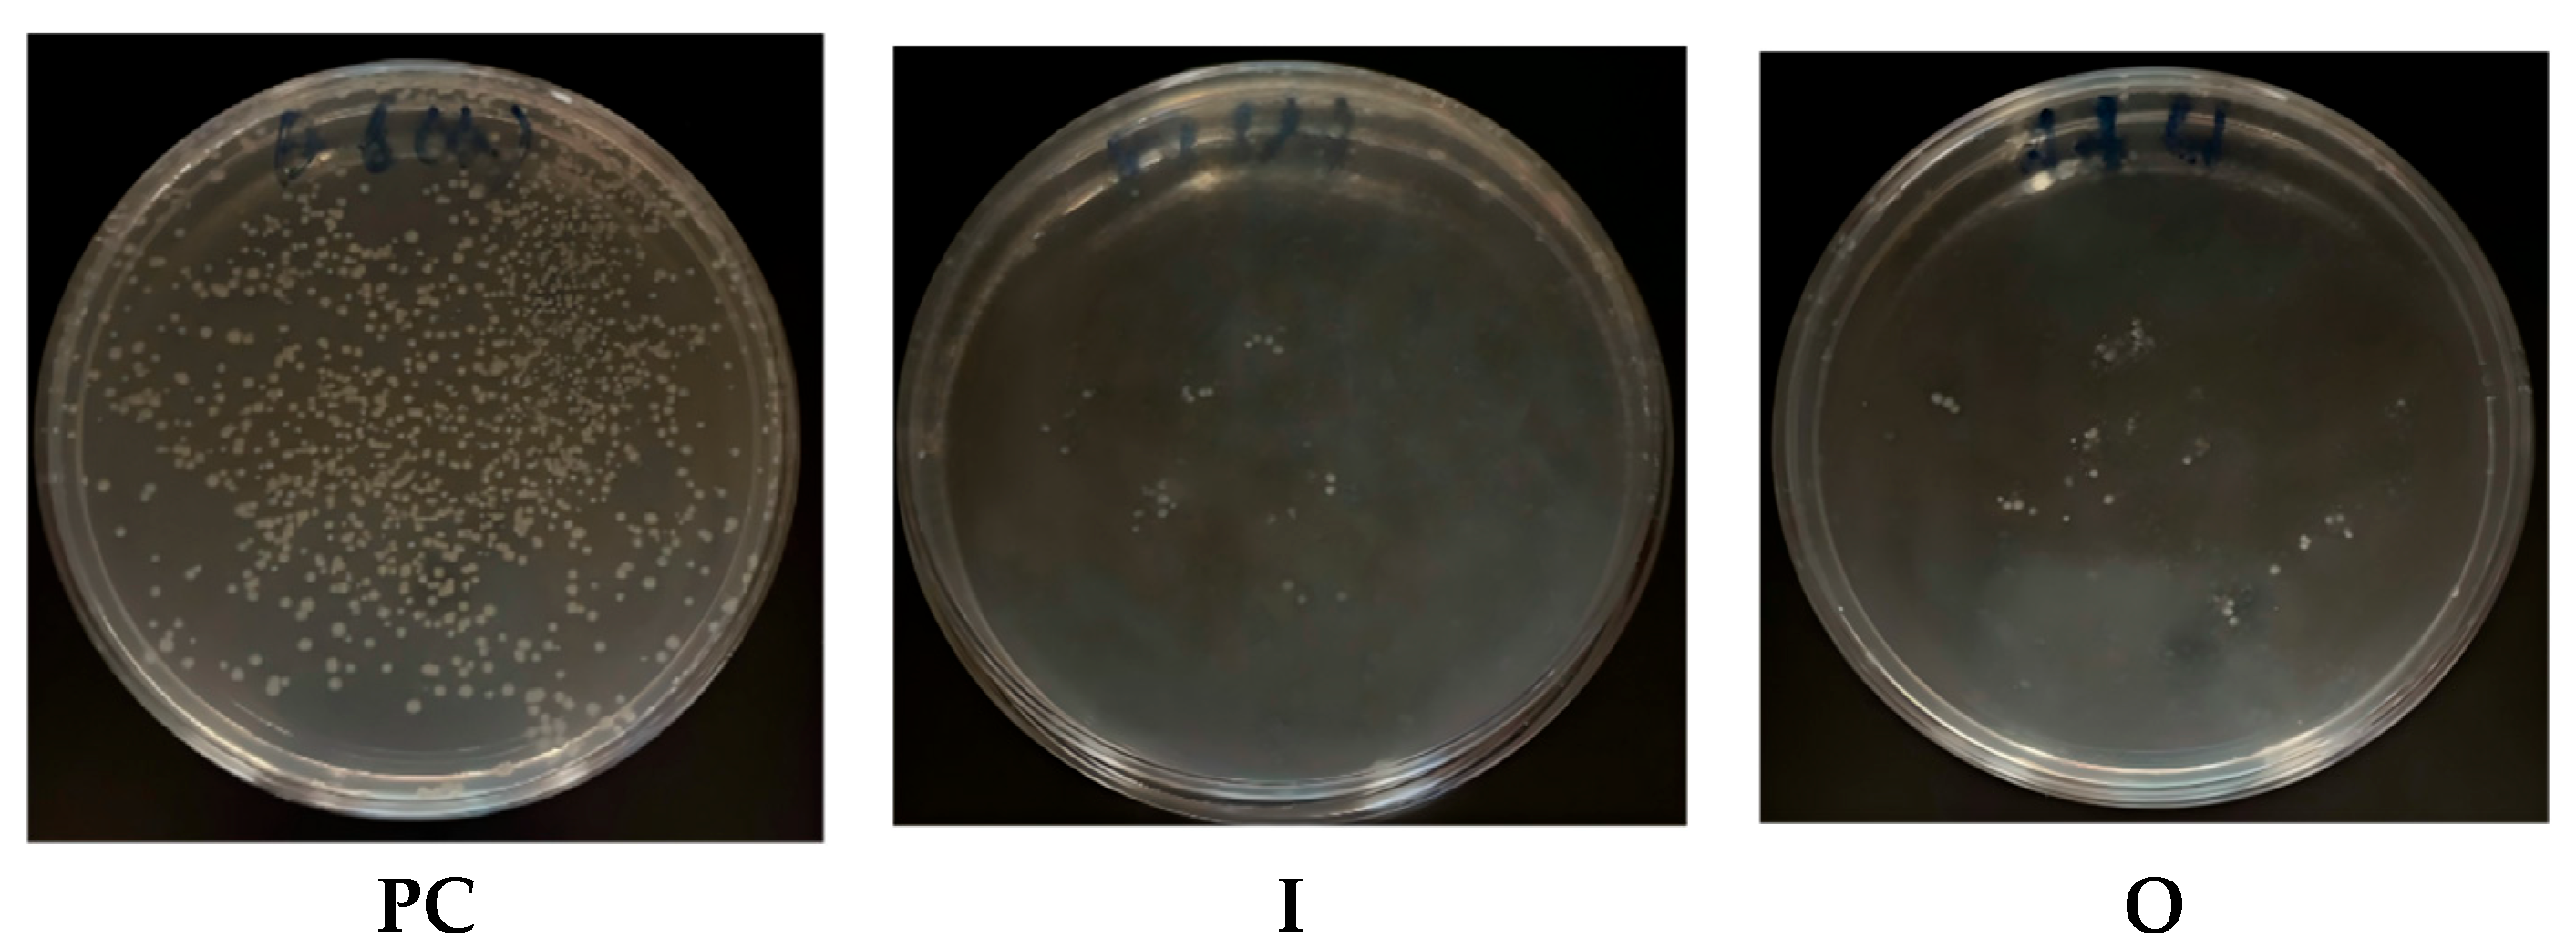
Coatings 15 00936 g010 Coatings 15 00936 g010

Study of Polyhedral Oligomeric Silsesquioxane-Modified Superwetting Transparent Coating for Anti-Fogging, Stain Resistance, Self-Cleaning and Anti-Biological Application
Abstract
1. Introduction
2. Experimental Section
2.1. Materials
2.2. Preparation Process
2.2.1. Preparation of POSS-SH4-(PEGMA)4
2.2.2. Preparation of POSS-SH-(DFMA)7
2.2.3. Preparation of the Coatings
2.3. Characterization
2.3.1. Surface Wettability
2.3.2. Transmittance
2.3.3. Scanning Electron Microscopy (SEM)
2.3.4. Modeling of Water Droplets on the Surface of the Coating
2.3.5. Anti-Fogging
2.3.6. Stain Resistance
2.3.7. Self-Cleaning
2.3.8. Anti-Biological Application
3. Results and Discussions
3.1. Surface Structure, Wettability and Transmittance
3.2. Construction of Water Droplet on Coating Surface Model
3.3. Anti-Fogging Performance
3.4. Stain Resistance
3.5. Self-Cleaning
3.6. Anti-Biological Application
4. Conclusions
Supplementary Materials
Author Contributions
Funding
Institutional Review Board Statement
Informed Consent Statement
Data Availability Statement
Acknowledgments
Conflicts of Interest
References
- Long, M.; Ma, Y.; Yang, C.; Zhang, R.; Jiang, Z. Superwetting membranes: From controllable constructions to efficient separations. J. Mater. Chem. A 2021, 9, 1395–1417. [Google Scholar] [CrossRef]
- Zhang, H.Y.; Wang, F.Y.; Guo, Z.G. The antifouling mechanism and application of bio-inspired superwetting surfaces with effective antifouling performance. Adv. Colloid Interface Sci. 2024, 325, 103097. [Google Scholar] [CrossRef] [PubMed]
- Shigrekara, M.; Amdoskar, V. A review on recent progress and techniques used for fabricating superhydrophobic coatings derived from biobased materials. RSC Adv. 2024, 14, 32668–32699. [Google Scholar] [CrossRef]
- Yoon, J.; Ryu, M.; Kim, H.; Ahn, G.N.; Yim, S.J.; Kim, D.P.; Lee, H. Wet-style superhydrophobic antifogging coatings for optical sensors. Adv. Mater. 2020, 32, 2002710. [Google Scholar] [CrossRef] [PubMed]
- Ding, Y.; Zhang, H.; Wang, Y.; Li, J.; Zheng, Y. Fabrication of a superhydrophobic porous electrode with voltage-induced anti-fogging properties. RSC Adv. 2025, 15, 17435–17441. [Google Scholar] [CrossRef]
- Kaindl, R.; Hendler, C.; Homola, T.; Vida, J.; Belegratis, M.; Lackner, J.M.; Waldhauser, W. Superhydrophobic and photocatalytic self-cleaning surfaces by atmospheric pressure plasma jet deposited hydroxyapatite, titanium-dioxide silicone-like multilayers. Surf. Coat. Technol. 2025, 511, 132265. [Google Scholar] [CrossRef]
- Latthe, S.S.; Sutar, R.S.; Kodag, V.S.; Bhosale, A.K.; Kumar, A.M.; Sadasivuni, K.K.; Xing, R.; Liu, S. Self-cleaning superhydrophobic coatings: Potential industrial applications. Prog. Org. Coat. 2019, 128, 52–58. [Google Scholar] [CrossRef]
- Shang, Q.; Chen, J.; Liu, C.; Hu, Y.; Hu, L.; Yang, X.; Zhou, Y. Facile fabrication of environmentally friendly bio-based superhydrophobic surfaces via UV polymerization for self-cleaning and high efficient oil/water separation. Prog. Org. Coat. 2019, 137, 105346. [Google Scholar] [CrossRef]
- Esmeryan, K.D.; Castano, C.E.; Mohammadi, R.; Lazarov, Y.; Radeva, E.I. Delayed condensation and frost formation on superhydrophobic carbon soot coatings by controlling the presence of hydrophilic active sites. J. Phys. D Appl. Phys. 2018, 51, 55302. [Google Scholar] [CrossRef]
- Cao, H.; Fu, J.; Liu, Y.; Chen, S. Facile design of superhydrophobic and superoleophilic copper mesh assisted by candle soot for oil water separation. Colloids Surfurfaces A Physicochem. Eng. Asp. 2018, 537, 294–302. [Google Scholar] [CrossRef]
- Chauhan, P.; Kumar, A.; Bhushan, B. Self-cleaning, stain-resistant and anti-bacterial superhydrophobic cotton fabric prepared by simple immersion technique. J. Colloid Interface Sci. 2019, 535, 66–74. [Google Scholar] [CrossRef]
- Wu, M.; Ma, B.; Pan, T.; Chen, S.; Sun, J. Silver-nanoparticle-colored cotton fabrics with tunable colors and durable antibacterial and self-healing superhydrophobic properties. Adv. Funct. Mater. 2016, 26, 569–576. [Google Scholar] [CrossRef]
- Zulfiqar, U.; Hussain, S.Z.; Subhani, T.; Hussain, I. Mechanically robust superhydrophobic coating from sawdust particles and carbon soot for oil/water Separation. Colloids Surfurfaces A Physicochem. Eng. Asp. 2018, 539, 391–398. [Google Scholar] [CrossRef]
- Mi, H.Y.; Li, H.; Jing, X.; Zhang, Q.; Feng, P.Y.; He, P.; Liu, Y. Robust superhydrophobic fluorinated fibrous silica sponge with fire retardancy for selective oil absorption in harsh environment. Sep. Purif. Technol. 2020, 241, 116700. [Google Scholar] [CrossRef]
- Chevallier, P.; Turgeon, S.; Sarra-Bournet, C.; Turcotte, R.; Laroche, G. Characterization of multilayer anti-fog coatings. ACS Appl. Mater. Interfaces 2011, 3, 750–758. [Google Scholar] [CrossRef] [PubMed]
- Darmanin, T.; Guittard, F. Recent advances in the potential applications of bioinspired superhydrophobic materials. J. Mater. Chem. A 2014, 2, 16319–16359. [Google Scholar] [CrossRef]
- Power, A.C.; Barrett, A.; Abubakar, J.; Suarez, L.J.; Ryan, L.; Wencel, D.; Sullivan, T.; Regan, F. Versatile self-cleaning coating production through sol-gel chemistry. Adv. Eng. Mater. 2016, 18, 76–82. [Google Scholar] [CrossRef]
- El-Mahallawi, I.; Elshazly, E.; Ramadan, M.; Nasser, R.; Yasser, M. Solar PV panels-self-cleaning coating material for egyptian climatic conditions. Sustainability 2022, 14, 11001. [Google Scholar] [CrossRef]
- Luo, X.; Lu, L.; Yin, M.; Fang, X.; Chen, X.; Li, D.; Yang, L.; Li, G.; Ma, J. Antireflective and self-cleaning glass with robust moth-eye surface nanostructures for photovoltaic utilization. Mater. Res. Bull. 2019, 109, 183–189. [Google Scholar] [CrossRef]
- Thompson, C.S.; Fleming, R.A.; Zou, M. Transparent self-cleaning and antifogging silica nanoparticle films. Sol. Energy Mater. Sol. Cells 2013, 115, 108–113. [Google Scholar] [CrossRef]
- Tanaka, K.; Chujo, Y. Advanced functional materials based on polyhedral oligomeric silsesquioxane (POSS). J. Mater. Chem. 2012, 22, 1733–1746. [Google Scholar] [CrossRef]
- Zhang, W.J.; Camino, G.; Yang, R.J. Polymer/polyhedral oligomeric silsesquioxane (POSS) nanocomposites: An overview of fire retardance. Prog. Polym. Sci. 2017, 67, 77–125. [Google Scholar] [CrossRef]
- Chang, Y.K.; Hao, S.J.; Wu, F.G. Recent biomedical applications of functional materials based on polyhedral oligomeric silsesquioxane (POSS). Small 2024, 20, 2401762. [Google Scholar] [CrossRef]
- Xu, X.T.; Wang, T.; Sun, Q.W. Effect of Molecular Weight and Annealing Treatment on Mechanical and Thermal Properties of Polycarbonate. Polym. Mater. Sci. Eng. 2024, 40, 92–99. [Google Scholar]
- Ju, J.; Bai, H.; Zheng, Y.; Zhao, T.; Fang, R.; Jiang, L. A multi structural and multi-functional integrated fog collection system in cactus. Nat. Commun. 2012, 3, 1247–1252. [Google Scholar] [CrossRef]
- Liu, G.; Xia, H.; Yan, M.; Song, L.; Li, H.; Niu, Y. Performance and mechanism of self-cleaning synergistic photocatalytic coating inhibiting NO2 for green degradation of NO. Appl. Surf. Sci. 2022, 586, 152787. [Google Scholar] [CrossRef]
- Zhu, W.; Wu, C.; He, J.; Dong, X. Study of polyhedral oligomeric silsesquioxane-modified superhydrophilic transparent coating in antifogging, antifrost and self-cleaning. Polymers 2025, 17, 599. [Google Scholar] [CrossRef]
- Wang, P.; Jin, Y.; Pi, P.H.; Wen, X.F.; Xu, S.P.; Cheng, J. Surface microphase separation and hydrophobicity of POSS based fluorinated acrylate copolymer. Acta Polym. Sin. 2017, 4, 700–707. [Google Scholar]
- Sun, L.; Guo, J.; Chen, H.; Zhang, D.; Shang, L.; Zhang, B.; Zhao, Y. Tailoring materials with specific wettability in biomedical engineering. Adv. Sci. 2021, 8, 2100126. [Google Scholar] [CrossRef] [PubMed]
- Li, Z.; Liu, Y.; Wu, Y.; Zhou, F. Biomimetic superwetting phenomena for antifogging surfaces. Langmuir 2025, 41, 8425–8450. [Google Scholar] [CrossRef] [PubMed]
- Latthe, S.S.; Gurav, A.B.; Maruti, C.S.; Vhatkar, R.S. Recent progress in preparation of superhydrophobic surfaces: A review. J. Surf. Eng. Mater. Adv. Technol. 2012, 2, 76–94. [Google Scholar] [CrossRef]
- Ke, S.; Li, J.; Li, R.; Zhu, J.; Chen, Y.; Hu, J.; Lai, Y.; Huang, J.; Wu, X.; Chen, Z. Recent developments in the fabrication, performance, and application of transparent superhydrophobic coatings. Adv. Colloid Interface Sci. 2025, 342, 103537. [Google Scholar] [CrossRef] [PubMed]
- Jin, H.C.; Bing, W.; Jin, E.; Tian, L.; Jiang, Y. Bioinspired PDMS-phosphor-silicone rubber sandwich-structure coatings for combating biofouling. Adv. Mater. Interfaces 2020, 7, 201901577. [Google Scholar] [CrossRef]
- Yoon, J.; Zhang, X.; Ryu, M.; Kim, W.H.; Ihm, K.; Lee, J.W.; Li, W.; Lee, H. Tailoring the hydrophilicity for delayed condensation frosting in antifogging coatings. ACS Appl. Mater. Interfaces 2022, 14, 35064–35073. [Google Scholar] [CrossRef]

Disclaimer/Publisher’s Note: The statements, opinions and data contained in all publications are solely those of the individual author(s) and contributor(s) and not of MDPI and/or the editor(s). MDPI and/or the editor(s) disclaim responsibility for any injury to people or property resulting from any ideas, methods, instructions or products referred to in the content. |
© 2025 by the authors. Licensee MDPI, Basel, Switzerland. This article is an open access article distributed under the terms and conditions of the Creative Commons Attribution (CC BY) license (https://creativecommons.org/licenses/by/4.0/).
Share and Cite
Zhu, W.; He, J.; Dong, X. Study of Polyhedral Oligomeric Silsesquioxane-Modified Superwetting Transparent Coating for Anti-Fogging, Stain Resistance, Self-Cleaning and Anti-Biological Application. Coatings 2025, 15, 936. https://doi.org/10.3390/coatings15080936
Zhu W, He J, Dong X. Study of Polyhedral Oligomeric Silsesquioxane-Modified Superwetting Transparent Coating for Anti-Fogging, Stain Resistance, Self-Cleaning and Anti-Biological Application. Coatings. 2025; 15(8):936. https://doi.org/10.3390/coatings15080936
Chicago/Turabian StyleZhu, Weibiao, Jinxin He, and Xia Dong. 2025. "Study of Polyhedral Oligomeric Silsesquioxane-Modified Superwetting Transparent Coating for Anti-Fogging, Stain Resistance, Self-Cleaning and Anti-Biological Application" Coatings 15, no. 8: 936. https://doi.org/10.3390/coatings15080936
APA StyleZhu, W., He, J., & Dong, X. (2025). Study of Polyhedral Oligomeric Silsesquioxane-Modified Superwetting Transparent Coating for Anti-Fogging, Stain Resistance, Self-Cleaning and Anti-Biological Application. Coatings, 15(8), 936. https://doi.org/10.3390/coatings15080936
